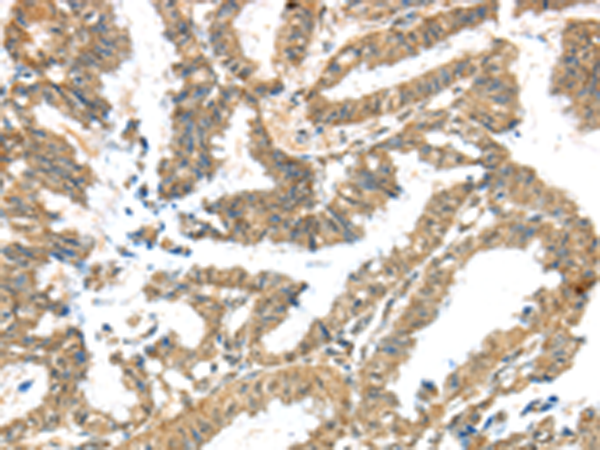

|
Background: |
Voltage-gated potassium (Kv) channels represent the most complex class of voltage-gated ion channels from both functional and structural standpoints. Their diverse functions include regulating neurotransmitter release, heart rate, insulin secretion, neuronal excitability, epithelial electrolyte transport, smooth muscle contraction, and cell volume. This gene encodes a member of the potassium channel, voltage-gated, subfamily G. This member is a gamma subunit functioning as a modulatory molecule. Alternative splicing results in two transcript variants encoding distinct isoforms. |
|
Applications: |
ELISA, IHC |
|
Name of antibody: |
KCNG3 |
|
Immunogen: |
Synthetic peptide of human KCNG3 |
|
Full name: |
potassium voltage-gated channel, subfamily G, member 3 |
|
Synonyms: |
KV6.3; KV10.1 |
|
SwissProt: |
Q8TAE7 |
|
ELISA Recommended dilution: |
2000-10000 |
|
IHC positive control: |
Human colon cancer and Human liver cancer |
|
IHC Recommend dilution: |
50-200 |
購(gòu)物車(chē)
幫助
021-54845833/15800441009
